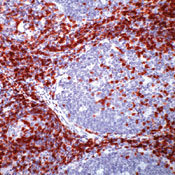

|
| ||||||
| |||||||
| / Каталог / Иммунология / Иммуногистохимия / Реагенты для иммуногистохимии / Моноклональные антитела (кроличьи) | |||||||||||||||||||||||||||
Моноклональные кроличьи антитела к CD5CD5 (clone SP19)Спецификация
Информация для заказа
| |||||||||||||||||||||||||||
|
|
© ООО «Лабораторная Диагностика» info@LD.ru тел.: +7 495 369-20-43 |
Наименование: Моноклональные кроличьи антитела к CD5 / CD5 (clone SP19) .
Наименование: Моноклональные кроличьи антитела к CD5 / CD5 (clone SP19) .